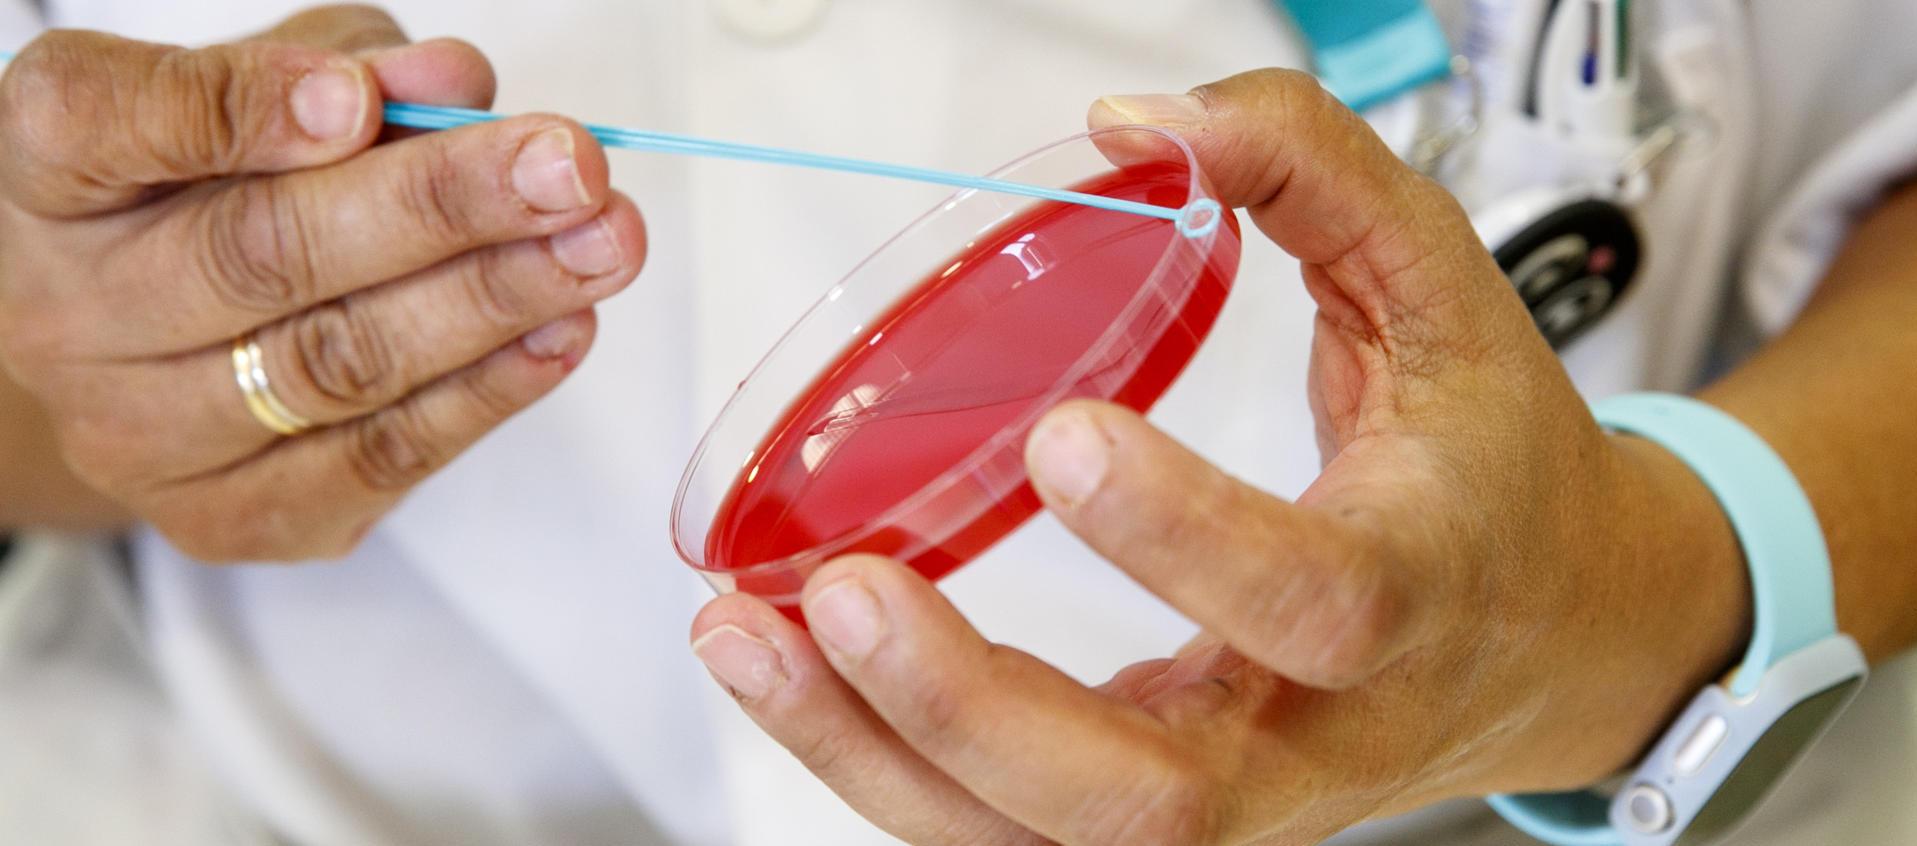
Personal técnico de laboratorio prepara unas muestras para analizar, en una imagen de archivo

Logran vacuna de polvo que previene el Covid-19 en animales: requiere una sola dosis
Fue ensayada en ratones, hámsters y primates no humanos.
Científicos chinos han desarrollado una vacuna para el Covid-19 que se inhala y llega a los pulmones en forma de polvo seco y cuyo compuesto provoca una importante respuesta inmunitaria que previene la infección en ratones, hámsters y primates no humanos.
Los detalles de esta candidata a vacuna, desarrollada por el equipo de Guanghui Ma, de la Academia China de Ciencias de Beijing, se han publicado este miércoles en la revista Nature.
Desde el inicio de la pandemia, a principios de 2020, se han hecho numerosos esfuerzos para desarrollar y aprobar vacunas contra el virus del SARS-CoV-2 causante del Covid-19.
La mayoría de las vacunas que han tenido éxito se administran mediante inyecciones intramusculares que provocan la producción de anticuerpos y reducen los síntomas de la enfermedad.
Pero estas vacunas no son capaces de prevenir la infección porque no logran inmunizar a los tejidos de las vías respiratorias (por donde entra el virus al organismo).
Además, estas vacunas líquidas tienen que conservarse y almacenarse en frío, lo que tiene un coste adicional.
El artículo de Nature detalla el trabajo del equipo de Guanghui Ma, quien ha desarrollado una vacuna inhalable en aerosol de polvo seco contra el SARS-CoV-2 que se administra en una sola dosis y confiere inmunidad en las mucosas.
La vacuna encapsula una proteína bacteriana no tóxica llamada CTB, modificada para mostrar el antígeno del dominio de unión al receptor del SARS-CoV-2, dentro de microcápsulas lo suficientemente pequeñas como para entrar y depositarse en las profundidades de los pulmones.
Esta estructura 'nano' favorece la llegada del compuesto a los alvéolos, la liberación sostenida del antígeno y la inducción de la respuesta inmunitaria.
Además, el equipo probó la vacuna tanto con virus ancestrales como con la variante Omicron, para probar su eficacia contra múltiples cepas.
En una dosis única, el prototipo se administró eficazmente en el tejido mucoso de los pulmones y mostró una liberación sostenida del antígeno y una captación satisfactoria por las células presentadoras de antígeno.
También indujo un aumento a largo plazo de la producción de IgG e inmunoglobulina A (IgA) en ratones, hámsters y primates no humanos, lo que proporciona una protección eficaz contra la infección por SARS-CoV-2.
Además, el polvo demostró ser estable a temperatura ambiente tras un mes de almacenamiento, lo que podría reducir los costes de almacenamiento y transporte de la distribución de la vacuna, haciéndola así más accesible.
Para los autores, esta vacuna inhalada es una "prometedora" vía para prevenir el Covid-19 porque se dirige directamente a las células pulmonares, induciendo una respuesta inmunitaria más robusta que las vacunas anteriores.
A su juicio, estos resultados respaldan el uso de esta vacuna, cuyo sistema de administración en aerosol tiene potencial como herramienta para combatir tanto la Covid-19 como otras enfermedades respiratorias, concluye el estudio.
En un "News & Views" publicada en Nature, los expertos en prevención pandémica del Centro de Investigación Inmunológica de la Universidad McMaster de Ontario (Canadá), Zhou Xing y Mangalakumari Jeyanathan, apuntan que, "aunque la seguridad y la potencia inmunitaria de la vacuna aún no se ha comprobado en ensayos clínicos en humanos, si tienen éxito, ofrecería una forma racionalizada de administrar una vacuna capaz de inmunizar la mucosa respiratoria".
Ambos investigadores destacan también que a diferencia de otros métodos de administración como el spray nasal o el nebulizador, que necesitan mantener la cadena del frío para su conservación, el inhalador de polvo seco es una solución que permanece estable a temperatura ambiente durante al menos un mes.
Eso, sí, apuntan, "sería importante determinar cuánto dura esa estabilidad y cómo afectaría la degradación de la vacuna a la inmunidad que confiere".
EFE




